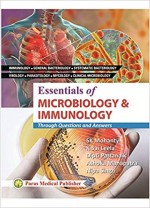
Essentials of Microbiology and Immunology: Through Questions and Answers

Om Publications
Essentials of Microbiology and Immunology: Through Questions and Answers
S.K. Mohanty, K. Sai Leela, Dipti Pattanaik, Ashoka Mahakpatra and Nipa Singh
₹1074 ₹1095 (2% off)
ISBN 13
9788181915047
Year
2019
The book presents an updated and complete set of questions and answers covering all aspects of the subject which a student must know. Comprises fields such as immunology, general bacteriology, systemic bacteriology, virology, parasitology, mycology and clinical microbiology. Includes illustrative graphic, coloured diagrams, flow charts and table to make the answers lucid and interesting. The book serves a great purpose in solving the problems of assimilation and reproduction of answers to the point precisely and comprehensively without losing the essentials. The provided categories (long essay, short notes, brief answers to questions, multiple choice questions and answers) will be of great help while preparing for various competitive entrance examinations. Spans the curriculam of medical, dental and other allied courses (basic and applied). Also included are over 300 colour illustrations. Perfect for classroom learning and preparation for tests, especially at the time of examination for self-assessment and review.